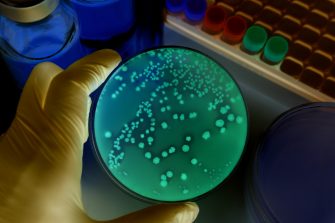
Close up of network data flowing through nanowires.
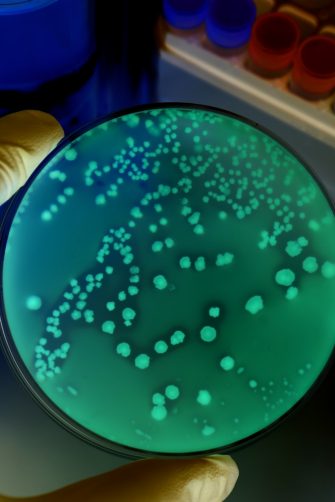
Close up of network data flowing through nanowires.

Filaments engineered by scientists at UNSW Sydney were shown to produce electricity from moisture in the air.
Engineered protein filaments originally produced by bacteria have been modified by scientists to conduct electricity.
In a study published recently in the journal Small, researchers revealed that protein nanowires – which were modified by adding a single compound – can conduct electricity over short distances and harness energy from moisture in the air.
“Our findings open up possibilities for developing sustainable and environmentally friendly electrical components and devices, based on proteins,” says Dr Lorenzo Travaglini, lead author on the paper. “These engineered nanowires could one day lead to innovations in energy harvesting, biomedical applications and environmental sensing.”
Developments in the interdisciplinary field that combines protein engineering and nanoelectronics also hold promise for developing cutting-edge technologies that bridge the gap between biological systems and electronic devices.
“Ultimately, our goal is to modify the materials produced by bacteria to create electronic components. This could lead to a whole new era of green electronics, helping to shape a more sustainable future,” says Dr Travaglini, who is supervised by Dr Dominic Glover in the SYNbioLAB from the School of Biotechnology and Biomolecular Sciences.
Media enquiries
For enquiries about this story and to arrange interviews please contact Lilly Matson.
Tel: 042 656 007
Email: l.matson@unsw.edu.au
Taking inspiration from nature
Electricity is created by the movement of electrons – small particles that carry an electric charge – between atoms.
“Lots of events in nature require the movement of electrons and are the source of inspiration for new electricity harvesting techniques,” says Dr Travaglini. “For example, chlorophyll in plants needs to move electrons between different proteins in order to photosynthesise.”
Naturally occurring bacteria also use conductive filaments, known as nanowires, to transfer electrons across their membranes. Importantly, bacterial nanowires that conduct electricity have the potential to interact with biological systems, such as living cells, and could be used in biosensing to monitor internal signals from the body using a human-machine interface.
However, when extracted directly from bacteria, these natural nanowires are hard to modify and have limited functionality.
“To overcome these limitations, we genetically engineered a fiber using the bacteria E. coli,” says Dr Travaglini. “We modified the DNA of E. coli so that the bacteria not only produced the proteins that it needed to survive, but also built the specific protein we had designed, which we then engineered and assembled into nanowires in the lab.”
The team knew that by itself, the protein produced by the bacteria would not be highly conductive, but that they would need to add a single ingredient.
The missing part of the puzzle was a haem molecule.
Harnessing humidity to create energy
Haem is a circular structure – known as a porphyrin ring – with an iron atom that sits in the middle. It is responsible for carrying oxygen in red blood cells from the lungs to the rest of the body.
Recent research has suggested that when haem molecules are arranged closely together, they enable electron transfer. So, Dr Travaglini and his team integrated haem into the filaments produced by the bacteria, suspecting that the electrons could jump between haem molecules if they were located close enough together.
In the lab, the team measured the conductance of the engineered filaments by laying a film of the material across an electrode and applying an electric potential. “As we had expected, we found that by adding haem to the filament, the protein became conductive, whereas the bare filament without the haem showed no current,” says Dr Travaglini.
While Dr Travaglini and Dr Glover had initially set out to modulate a naturally occurring material into a conductive wire, they discovered some surprising results.
“We ran the conductivity testing in a chamber where you can control the external conditions,” says Dr Travaglini. “We started to notice that under what is considered ‘ambient conditions’, between 20 – 30 per cent humidity, the electric current was stronger.”
The team decided to carry out more tests, using thicker amounts of the material, sandwiched between two gold electrodes. “We’ve proposed that the humidity created a gradient of charge across the depth of the material,” says Dr Travaglini. “And this unbalanced charge across the film is able to create a short current, without having to apply any potential at all.”
Once they discovered that the filament was responsive to humidity, they created a simple humidity sensor to measure how the current reacted to moisture in the air, by simply breathing onto the device. “We found that each peak in the conductivity of the fiber corresponded to an exhale,” says Dr Travaglini.
A step in the right direction
This research could open the door to the possibility of producing electrical devices sourced from sustainable and non-toxic materials that require ultra-low power.
“The electronics we tend to use are created through processes that require high temperatures and are very energy-demanding. They’re not green, and the materials they are sourced from can be toxic,” says Dr Travaglini. “Using biomaterials to create electricity is far more environmentally friendly. We can produce these filaments from bacteria, and it’s scalable.”
The properties of these protein assemblies could also be tunable by modulating the chemical structure of haem, or the surrounding environment of the filament. The team is currently experimenting with incorporating different porphyry molecules to change the material's properties, including light-sensitive ones. “This level of control is difficult to achieve with natural bacterial nanowires, highlighting the versatility and potential of our synthetic approach,” says Dr Travaglini.
Dr Travaglini highlights that his team is still in the early stages of research, and it could be a while off until we see these engineered filaments used in our everyday electronics. “It’s really matter of translation,” he says. “We don’t know how long exactly it’s going to take, but we can see that we are going in the right direction.”